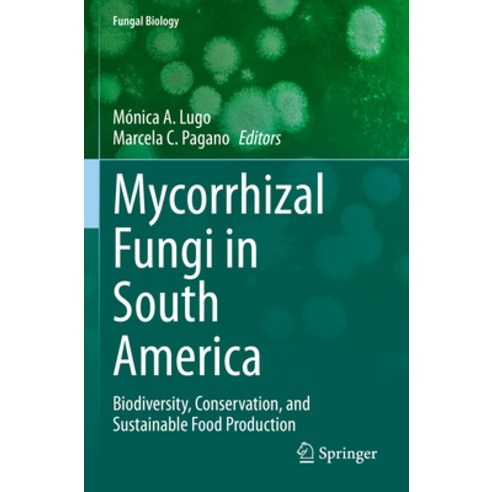
Product image

最近瀏覽商品
(英文圖書) Mycorrhizal Fungi in South America: Biodiversity Conservation and Sustainable Food Production 平裝版, Springer, 英文
9%
$4,011
$3,810
酷澎售價
$3,610
折扣後價格

7折
已套用優惠券
1/28 預計送達
賣家:Coupang Global LLC
刷卡優惠
查看銀行優惠活動 (回饋高達10%)
商品特色
- 深入了解南美洲菌根真菌的多樣性,探索其在生態保護中的重要作用。
- 透過本書,輕鬆掌握菌根真菌在永續糧食生產中的應用知識,提升農業生產力。
- 本書以簡潔易懂的語言,介紹菌根真菌的生物多樣性,適合各程度讀者閱讀。

商品概述
《南美洲菌根真菌:生物多樣性、保護與永續糧食生產》一書深入探討了南美洲地區菌根真菌的多樣性及其在生態系統中的關鍵作用。本書由Springer出版社出版,語言為英文,以平裝本形式呈現。讀者將了解到菌根真菌如何影響植物生長、土壤健康以及糧食生產。本書不僅適合科學研究人員,也適合對生態保護和永續農業感興趣的讀者。透過本書,您可以更深入地了解這些微小生物在地球生態系統中的重要性,並學習如何利用它們來改善我們的環境和糧食生產。
查看更多
商品標示資訊
查看所有標示資訊查看更多
商品評價
酷澎上販售之同一商品的商品評價,商品賣家可能有所不同。
酷澎上販售之同一商品的商品評價,商品賣家可能有所不同。
沒有商品評價。
商品諮詢
- 購買的商品 取消/退貨請在我的酷澎購買記錄中申請。
- 商品咨詢及評價板塊不處理取消或退貨事宜,請聯絡客服中心。
- 價格、賣家、換貨/退貨及配送等與商品本身無關的咨詢請使用客服中心的1:1咨詢。
- 「商品本身」無關的內容、轉讓、廣告、辱罵、洗版等內容可能會被移動、隱藏或刪除。
- 請不要在公開的咨詢板塊中留下您的電話號碼、郵箱地址等個人資訊。
目前尚無咨詢。
如您發現商品有不實廣告、侵害智慧財產權或其他不適合銷售之情形,請提出檢舉







